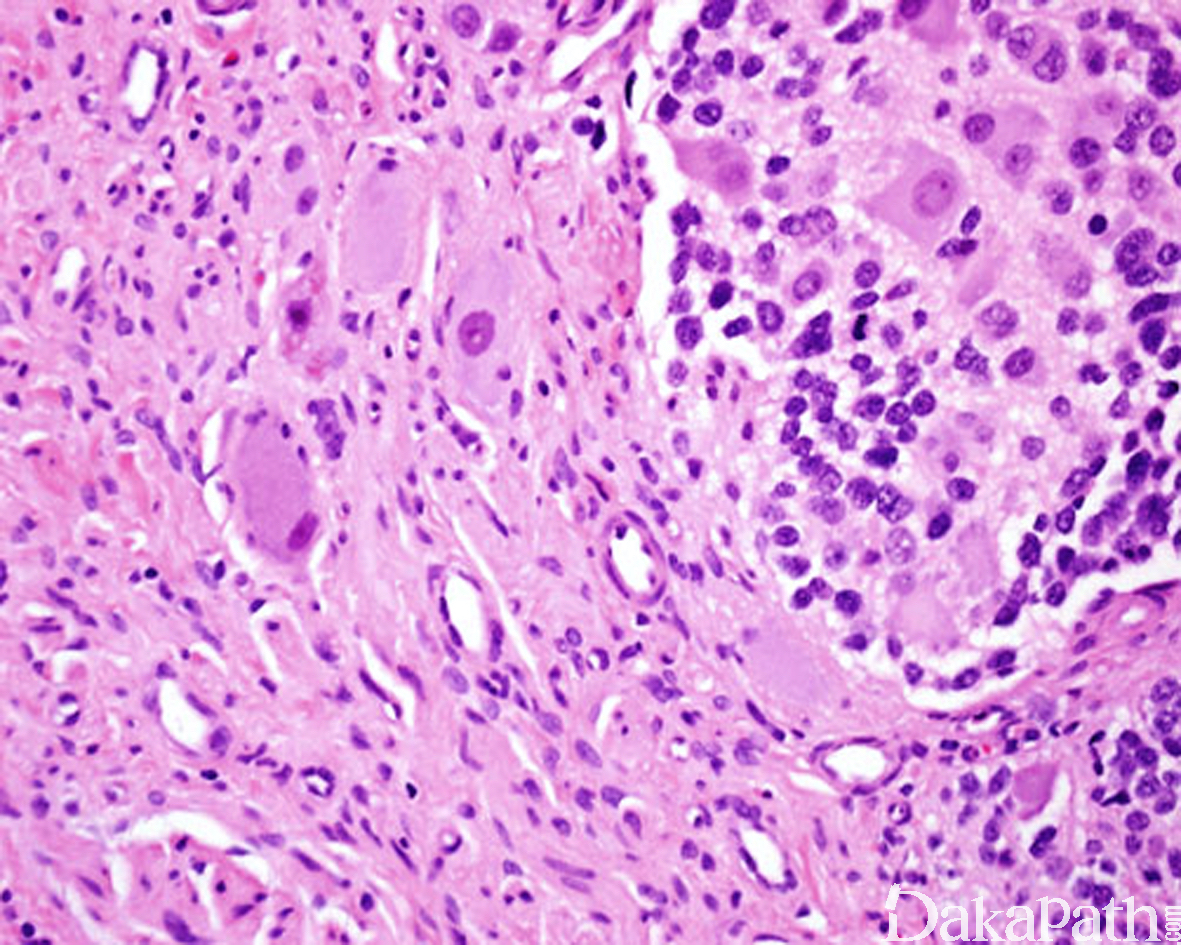

节细胞神经母细胞瘤
Ganglioneuroblastoma,GNB
诊断要点:
在神经母细胞瘤形态学基础上,部分区域细胞向节细胞分化;
组织学上有混合型和结节型两种类型:
混合型节细胞神经母细胞瘤,由界限相对清楚的神经母细胞肿瘤巢与丰富的节细胞神经瘤性成分组成,后者占肿瘤的 50%以上,神经母细胞肿瘤巢由不同分化阶段的神经母细胞(以分化型神经母细胞为主)和丰富的神经毡型间质组成;
结节型节细胞神经母细胞瘤:大体上能看到 1 个或多个神经母细胞性结节,通常伴出血或坏死,镜下见神经母细胞性结节与节细胞神经瘤成分之间有清晰的分界线。

免疫组织化学染色:
神经母细胞肿瘤细胞表达 NB84,PHXO2B,CGA,SYN,CD56,PGP9.5,NFP 等,神经鞘膜间质表达 S100 蛋白和 SOX10。
分子标记:
25%可见 N-MYC 扩增,FISH 用于检测
预后:
取决于分化程度
参考文献:
LAMA K.Update on adrenal tumours in 2017 World Health Organization (WHO) of endocrine tumours[J].Endocr Pathol,2017:1-15
← 微囊_网状型神经鞘瘤 神经鞘黏液瘤 →
